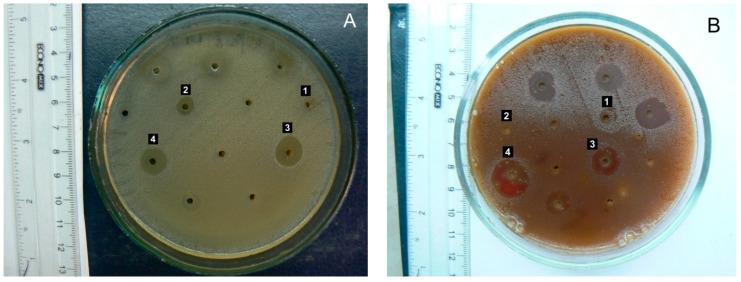
https://cdn.ncbi.nlm.nih.gov/pmc/blobs/c6bb/11768386/1f5a4f225762/plants-14-00219-g006.jpg

L. 草药提取物:植物化学成分与药理活性筛选。
L. Herb Extracts: Phytochemical Composition and Pharmacological Activity Screening.
作者信息
Maliuvanchuk Svitlana, Grytsyk Andriy, Popadynets Oksana, Kotyk Taras, Raal Ain, Koshovyi Oleh
机构信息
Department of Pharmaceutical Management, Drug Technology and Pharmacognosy, Ivano-Frankivsk National Medical University, 76000 Ivano-Frankivsk, Ukraine.
Department of Anatomy, Ivano-Frankivsk National Medical University, 76000 Ivano-Frankivsk, Ukraine.
出版信息
Plants (Basel). 2025 Jan 14;14(2):219. doi: 10.3390/plants14020219.
The genus (Lamiaceae family) comprises approximately 300 species, which are widely used in traditional medicine for their diaphoretic, antiseptic, hemostatic, and anti-inflammatory properties, but scarcely in official ones. Therefore, the study of holds promise for developing new medicinal products. In aqueous and aqueous-alcoholic soft extracts of the herb, 16 amino acids, 20 phenolics, and 10 volatile substances were identified by HPLC and GC/MS. The assays of the main substances' groups were also determined by spectrophotometry (vitamin K1, polyphenols, tannins, flavonoids, and hydroxycinnamic acids) and titrometry (ascorbic and organic acids). herb extracts are practically non-toxic, exhibit hepatoprotective activity (dose 25 mg/kg) in experimental carbon tetrachloride-induced hepatitis, moderate anti-inflammatory activity (dose 100 mg/kg) in carrageenan-induced edema models, and possess significant local hemostatic (reducing bleeding time by 40.6%) and wound-healing properties (complete wound healing after 9 days). The aqueous-ethanolic soft extract (extractant 50% ethanol) demonstrated the most pronounced hepatoprotective and anti-inflammatory effects. extracts are capable of inhibiting the growth of microorganisms and showing higher activity against Gram-positive bacteria. herb extracts are promising agents for implementation in official medicine as wound healing and hepatoprotective remedies after further preclinical and clinical studies.
该属(唇形科)约有300种植物,因其发汗、防腐、止血和抗炎特性而在传统医学中广泛使用,但在官方医学中却很少使用。因此,对该属植物的研究有望开发出新的药品。通过高效液相色谱法(HPLC)和气相色谱-质谱联用法(GC/MS),在该属植物的水提取物和水-醇软提取物中鉴定出了16种氨基酸、20种酚类化合物和10种挥发性物质。主要物质类别的含量测定也通过分光光度法(维生素K1、多酚、单宁、黄酮类化合物和羟基肉桂酸)和滴定法(抗坏血酸和有机酸)进行。该属植物提取物实际上无毒,在实验性四氯化碳诱导的肝炎中表现出肝保护活性(剂量为25毫克/千克),在角叉菜胶诱导的水肿模型中表现出中度抗炎活性(剂量为100毫克/千克),并具有显著的局部止血作用(出血时间缩短40.6%)和伤口愈合特性(9天后伤口完全愈合)。水-乙醇软提取物(提取剂为50%乙醇)表现出最明显的肝保护和抗炎作用。该属植物提取物能够抑制微生物生长,对革兰氏阳性菌显示出更高的活性。经过进一步的临床前和临床研究后,该属植物提取物有望作为伤口愈合和肝保护药物应用于官方医学。